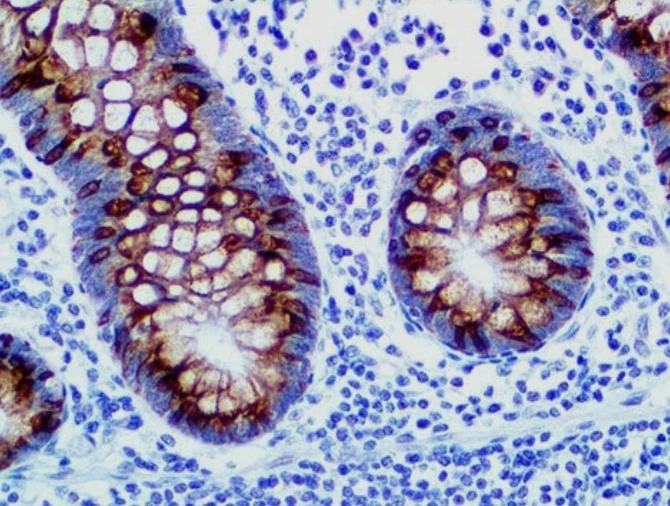
Immunohistochemistry: MUC2

تفاصيل التحليل
فحص بروتين الميوسين 2 الكيميائي النسيجي المناعي (MUC2)
تحليل نوعي لتشخيص الأورام المنتجة للمخاط في القولون والمبيض، مما يساهم في التصنيف الدقيق للورم واختيار البروتوكول العلاجي الأنسب لكل حالة طبية.
الصورة التوضيحية المرتبطة بهذا التحليل